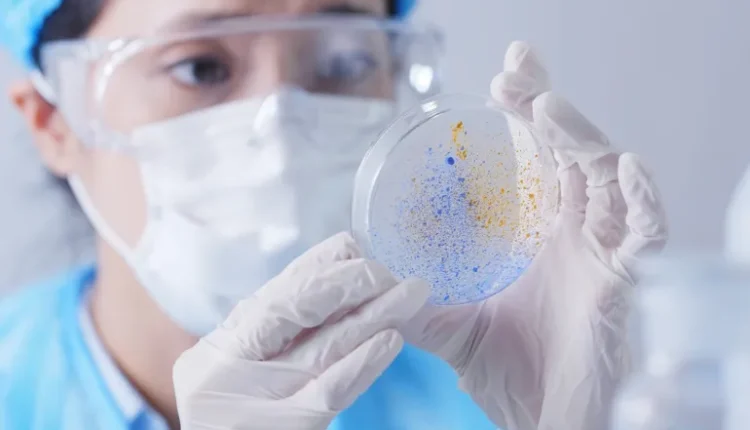

باحثون صينيون: البكتيريا قد تجعل تربة القمر زراعية
نظرا لأن العديد من الدول تخطط لإعادة البشر إلى القمر، فإنه يجب عليها معالجة العديد من المشكلات، وأحد أبسط تلك المشكلات اكتشاف طريقة لإطعام الأشخاص الذين يعملون هناك فترة طويلة من الزمن. والحل الواضح هو أن يقوم العاملون هناك بزراعة طعامهم بأنفسهم، لكن هذا يطرح مشكلات أيضا، مثل كيفية نقل التربة لزراعة النباتات الصالحة للأكل من الأرض إلى القمر.
مساع علمية لزراعة القمر
وخلال العام الماضي، أظهر فريق في الولايات المتحدة أنه من الممكن زراعة النباتات في القمر عن طريق زراعة عدد صغير من الأعشاب الضارة تسمى رشاد الثال في عينات التربة القمرية الحقيقية. وأظهر هذا الاختبار أن التربة القمرية يمكن أن تكون فعالة، ولكنها ليست جيدة بما يكفي لنضج النباتات وإنتاج الغذاء.
- Advertisement -
ومؤخرا، اكتشف فريق من المهندسين الزراعيين والفنيين الحيويين في جامعة الصين الزراعية أن إضافة البكتيريا إلى الثرى القمري المحاكى يزيد من كمية الفوسفات في التربة لاستخدامها من قبل النباتات.
وفي دراستهم التي نشرت في دورية “كوميونيكيشنز بيولوجي”، أضافت المجموعة 3 أنواع من البكتيريا إلى عينات من المواد البركانية ثم اختبرتها فيما يتعلق بالحموضة وقدرتها على دعم زراعة النباتات. ووجد فريق البحث أن إضافة الميكروبات إلى التربة القمرية يمكن أن يحسن قدرتها على استضافة الحياة النباتية.
- Advertisement -

ثلاثة أنواع من البكتيريا
ولاختبار إمكانية استخدام الميكروبات مثل البكتيريا لجعل الثرى القمري أكثر ملاءمة للحياة النباتية، حصل فريق البحث على عينات من المواد البركانية من جبل في الصين، ويشير تقرير منشور على موقع “فيز دوت أورغ” أن الاختبار أظهر أنها بديل معقول للثرى الصخري القمري. ثم أضاف الباحثون واحدا من ثلاثة أنواع من البكتيريا إلى ثلاثة أوعية اختبار مملوءة بالمواد البركانية، وهي بكتيريا الزائفة المتألقة، والعصية الضخمة، والعصية المخاطية.
وبعد زراعة البكتيريا في عينات التربة، قام الباحثون باختبار العينات لمعرفة التأثيرات. ووجدوا أن إضافة الأنواع الثلاثة من البكتيريا جعلت عينات التربة أكثر حمضية، مما أدى إلى انخفاض مستوى الرقم الهيدروجيني للتربة. وأدى ذلك إلى إذابة المعادن غير القابلة للذوبان المحتوية على الفوسفات في التربة، مما أدى إلى إطلاق الفوسفور، مما يجعله متاحا للنباتات.
ثم قام فريق البحث بإجراء اختبار مباشر للتربة المعالجة عن طريق زراعة نبات اسمه “نيكوتيانا بنثاميانا”، ووجدوا أن التربة المحسنة تنتج نباتات ذات جذور أكثر قوة وسيقان أطول وأوراق أكبر مقارنة بالعينات غير المعالجة.
المصدر : فيز دوت أورغ

التعليقات مغلقة.